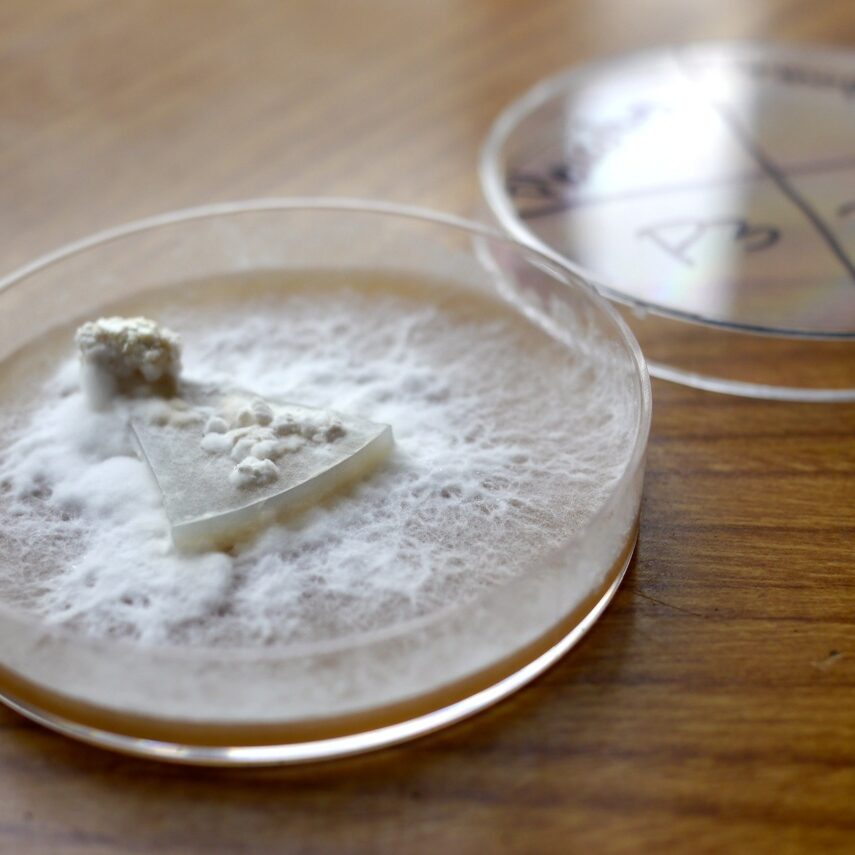

Gourmet Mushroom Cultivation Workshop
This course was two jam-packed days of hands-on skills in edible mushroom propagation. Students learnt how to grow delicious oyster, shiitake, pioppino, enoki, reishi (lingzhi), lions mane, king stropharia and many other mushrooms at home, organically!
Students were encouraged to learn techniques that minimise waste and energy use and focus on resilient processes that take advantage of the seasons and micro-climates around their property, rather than the conventional approach of single-use bags and expensive climate-controlled environments.
They also learnt advanced liquid culture techniques to avoid the expense of creating a sterile environment to make grain spawn.
By the end of this course students had the skills to take any suitable store-bought or foraged mushroom, clone and propagate it in a variety of ways, and create a lifetime supply of mushrooms with minimal start-up costs.
Topics covered included the biology and ecology of fungi, how to expand liquid culture syringes, how to make your own re-usable liquid culture equipment, ‘cloning’ store-bought mushrooms to make your own pure liquid cultures, producing spore prints and using them to produce new strains, duplicating liquid cultures so you can keep a master bank of different species, using liquid cultures to inoculate organic grain to make your own spawn, how to use that spawn to inoculate freely available materials to grow massive amounts of mushrooms, how to modify recycled containers to grow mushrooms while avoiding single-use plastics, how to create the right conditions to encourage your fungi to produce the best mushrooms, how to create a garden of giant mushrooms in your own backyard, and how to inoculate logs with sawdust and dowel spawn in order to grow the highest quality shiitake mushrooms